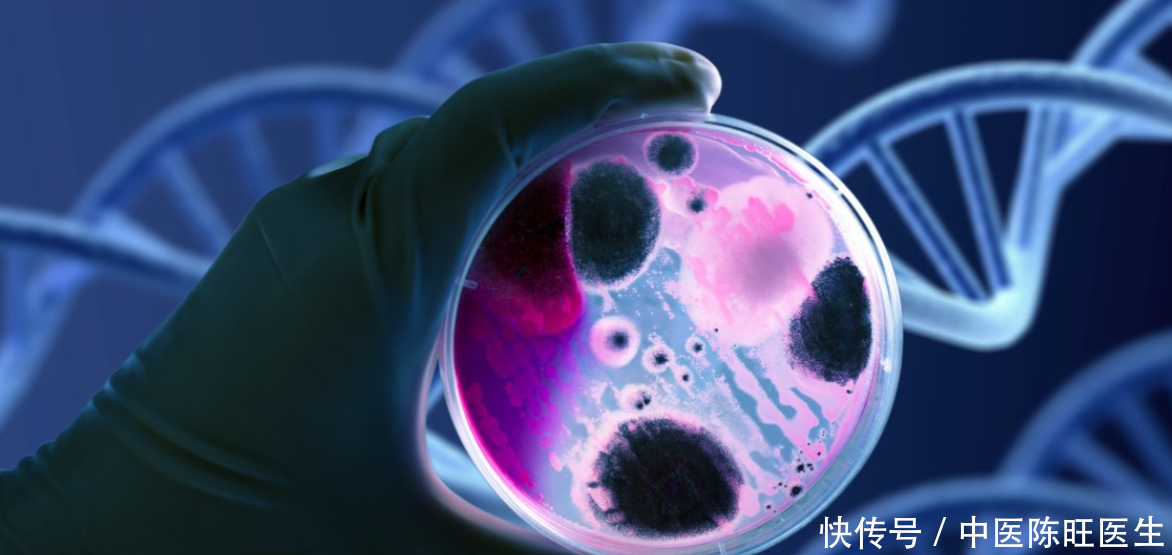

在癌症的治疗与康复过程中,患者常常面临一个令人困惑的问题——饮食忌口。社会上流传着诸多关于癌症患者饮食的“禁忌”,让不少患者及家属感到无所适从。对于癌症患者而言,是否真的必须遵循如此严苛的饮食约束呢?

一、为什么癌症患者需要关注饮食?
癌症,这一错综复杂的病症,不仅侵扰患者的生理机能平衡,更深度损伤免疫系统、消化系统等诸多体系,其影响广泛而深远。恰当的饮食策略,不仅能够为病患供给必需的营养基石,助力身体复原之旅,还能有效缓解治疗副作用,显著提升其生活品质与幸福感。

二、癌症患者的“真正”忌口
1. 辛辣食物
辛辣食材诸如辣椒、花椒、大蒜与洋葱,其强烈的刺激性或会加剧癌症患者的胃肠道承载压力,诱发恶心感、呕吐及腹部不适等不良反应。然而,值得注意的是,适量使用作为调味品,其轻微摄入通常不会带来显著的不良后果。鉴于胃肠道功能健全,癌症患者可基于自身条件,适量选择并享用适宜的食物。
2. 生冷食物
寒凉与未熟食品,诸如冰淇淋、生鱼片及牡蛎,或可对患者的消化系统产生不利影响,尤其当胃肠道功能呈现衰退迹象时,更应谨慎对待。另外,某些寒凉与生食可能潜藏有害微生物,进而提升罹患感染性疾病的风险。因此,癌症患者应尽量避免或少量食用生冷食物。
3. 油腻食物
高脂食品,包括肥肉、核桃、芝麻及花生等,其高脂肪含量可能加重胃肠道的消化负担,进而引发消化不适的症状。鉴于癌症患者普遍存在的身体机能减退状况,强调清淡饮食习惯、限制高脂食品摄入显得尤为重要。这并不意味着全面排斥,合理摄取优质脂肪源(例如鱼油与橄榄油)实则对维护身体健康大有裨益。

4. 酒精与熏烤类食物
酒精的双重危害在于,它既能侵害肝脏健康,又能激惹胃肠黏膜,进而显著提高癌症复发与扩散的风险性。熏烤类食物中含有一定量的致癌物质(如苯并芘),同样应避免食用。癌症患者应摒弃烟酒,积极拥抱并实践健康的生活方式。
5. 霉变与腌制食物
霉变食品内含霉菌,其产生的毒素对免疫与消化系统构成潜在威胁,可能引发严重损害。腌制食物中则含有较高的亚硝酸盐和多环芳烃等致癌物质,不利于病情控制。癌症患者应严格避免食用霉变和腌制食物,确保食物新鲜、卫生。

三、为癌症患者量身定制的膳食规划与建议
1. 多样化饮食
癌症患者需维持饮食的多元化,广泛摄取各类食物,以全面保障营养需求得到满足。推荐增加新鲜果蔬的摄入,这些满载维生素、矿物质及膳食纤维的自然佳品,对于强化免疫防线及优化消化机能具有显著助益。
2. 优质蛋白
优质蛋白质作为身体修复与强大免疫功能的基石,是维持生命活动不可或缺的关键营养要素。癌症患者应合理摄取鱼、禽、蛋、奶及豆制品等富含优质蛋白的食物,以充分满足身体的营养需求。
维持充足的水分摄入
确保足够的水分摄取对于保持身体代谢顺畅与有效排毒至关重要。癌症患者每日应维持足够的水分摄取量,有效防范脱水风险的产生。
遵循均衡饮食,避免过量进食
癌症患者应培养稳健的餐饮习惯,远离过量与急促的进食方式。提倡分次进食,每次少量且频繁,避免一餐过量,以减轻胃肠道的消化负荷。
精心挑选健康零食
明智挑选健康零食,能够为身体提供必要的能量补充与营养支持。癌症患者可以选择水果、奶制品、坚果等作为零食,但要避免辛辣、油腻、高糖、高盐的食物。

四、健康风险与预防方法
1. 营养不均衡的深远影响
长期陷入营养不均衡的困境,癌症患者的身体将承受沉重的代价。这种不均衡不仅削弱了机体的免疫系统,使其防线变得脆弱,难以有效抵御外界病原体的侵袭,从而显著增加了感染的风险。更为严重的是,营养不足还会直接影响治疗效果,使得抗癌治疗的效果大打折扣,甚至可能因体力不支而难以完成既定的治疗计划。
制定并实施一个全面而均衡的饮食计划显得尤为关键。这个计划应精心规划,确保患者能够摄取到足量的优质蛋白质,以支持细胞修复与免疫功能;同时,丰富的维生素与矿物质也是不可或缺的,它们对于维持身体正常代谢、促进药物吸收及减少副作用具有重要作用。
2. 消化系统的脆弱挑战
癌症治疗之旅常伴随着消化系统面临的重重挑战与考验。不良的饮食习惯犹若重负添霜,加剧了患者消化系统所承受的压力与负担。此举非但催生消化不良、腹胀等诸般不适,更可能诱发恶心呕逆之重症,深刻侵蚀患者的生活品质与安宁。
关键在于挑选温和且消化顺畅的膳食作为滋养之选。此列含括但不限于软糯米饭、细腻面条、清蒸鲜蔬及柔嫩易化之瘦肉等优选食材。并应竭力规避辛辣、油腻、生冷等易激消化道之物,以防症状益发加剧。推行分次少量进食,以分散单次消化负荷,实为减轻消化系统压力之佳法。
3. 对感染风险的严密把控与严峻防御策略的实施
癌症患者的免疫系统往往处于低下状态,这使得他们成为了细菌、病毒等微生物的易感人群。感染侵袭之际,病情或将急转直下,且易诱发多重并发症,置患者生命安全于险地。
患者应精选新鲜食材烹制佳肴,坚决摒弃过期与变质之食物。烹饪全程务必细致清洁食材与餐具,确保无虞于交叉污染之风险。个人卫生习惯的维持亦属至关重要之事。患者应养成频繁洗手之习惯,尤在食物接触前后;于公共场合或人群密集之地,佩戴口罩以降低感染之虞。采取上述诸项措施,旨在构筑一个安全无虞、益于健康之患者生活环境。
面对癌症,每一位患者和家属都承受着巨大的心理压力和身体负担。在这个过程中,合理的饮食不仅是身体的需要,更是心灵的慰藉。我们希望通过这篇文章,让每一位癌症患者都能明白:在饮食上,并没有那么多的“绝对禁忌”,只要遵循科学的饮食原则,保持营养均衡、清淡易消化,就能为身体提供足够的
友情提示
本站部分转载文章,皆来自互联网,仅供参考及分享,并不用于任何商业用途;版权归原作者所有,如涉及作品内容、版权和其他问题,请与本网联系,我们将在第一时间删除内容!
联系邮箱:1042463605@qq.com